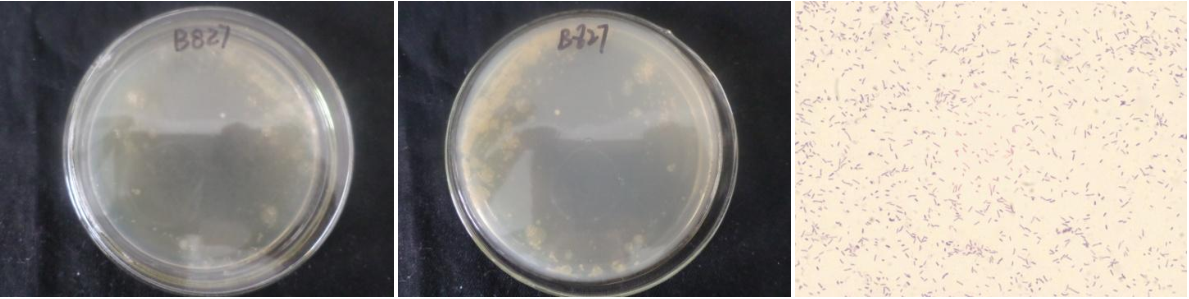

Loading...
| StrainNO | B827 |
| Classification | Pseudomonas |
| 16s rDNA sequence | GCAAGTCGAGCGGATGAAGGGAGCTTGCTCCCGGATTCAGCGGCGGACGGGTGAGTAATGCCTAGGAATCTGCCTGATAGTGGG GGACAACGTTTCGAAAGGAACGCTAATACCGCATACGTCCTACGGGAGAAAGCAGGGGACCTTCGGGCCTTGCGCTATCAGATG AGCCTAGGTCGGATTAGCTAGTTGGTGAGGTAATGGCTCACCAAGGCGACGATCCGTAACTGGTCTGAGAGGATGATCAGTCAC ACTGGAACTGAGACACGGTCCAGACTCCTACGGGAGGCAGCAGTGGGGAATATTGGACAATGGGCGAAAGCCTGATCCAGCCAT GCCGCGTGTGTGAAGAAGGTCTTCGGATTGTAAAGCACTTTAAGTTGGGAGGAAGGGCAGTAAGCTAATACCTTGCTGTTTTGA CGTTACCGACAGAATAAGCACCGGCTAACTTCGTGCCAGCAGCCGCGGTAATACGAAGGGTGCAAGCGTTAATCGGAATTACTG GGCGTAAAGCGCGCGTAGGTGGTTTGTTAAGTTGGATGTGAAAGCCCCGGGCTCAACCTGGGAACTGCATCCAAAACTGGCAAG CTAGAGTATGGCAGAGGGTGGTGGAATTTCCTGTGTAGCGGTGAAATGCGTAGATATAGGAAGGAACACCAGTGGCGAAGGCGA CCACCTGGGCTAATACTGACACTGAGGTGCGAAAGCGTGGGGAGCAAACAGGATTAGATACCCTGGTAGTCCACGCCGTAAACG ATGTCGACTAGCCGTTGGGATCCTTGAGATCTTAGTGGCGCAGCTAACGCATTAAGTCGACCGCCTGGGGAGTACGGCCGCAAG GTTAAAACTCAAATGAATTGACGGGGGCCCGCACAAGCGGTGGAGCATGTGGTTTAATTCGAAGCAACGCGAAGAACCTTACCA GGCCTTGACATGCTGAGAACCTGCCAGAGATGGCGGGGTGCCTTCGGGAACTCAGACACAGGTGCTGCATGGCTGTCGTCAGCT CGTGTCGTGAGATGTTGGGTTAAGTCCCGTAACGAGCGCAACCCTTGTCCTTAGTTACCAGCACGTTATGGTGGGCACTCTAAG GAGACTGCCGGTGACAAACCGGAGGAAGGTGGGGATGACGTCAAGTCATCATGGCCCTTACGGCCTGGGCTACACACGTGCTAC AATGGTCGGTACAAAGGGTTGCCAAGCCGCGAGGTGGAGCTAATCCCATAAAACCGATCGTAGTCCGGATCGCAGTCTGCAACT CGACTGCGTGAAGTCGGAATCGCTAGTAATCGTGAATCAGAATGTCACGGTGAATACGTTCCCGGGCCTTGTACACACCGCCCG TCACACCATGGGAGTGGGTTGCTCCAGAAGTAGCTAGTCTAACCTTCG |
| Strain Morphology Photos | |
| Morphological Description | Colony round;Spring yellow;edge neatly;steam bun shaped;slippy;sticky;Bacteriophage Rod-shaped;no spore |